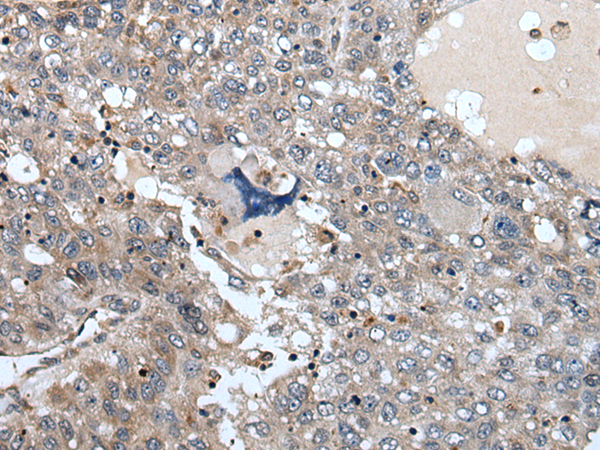

中文名稱: 兔抗WEE2多克隆抗體
英文名稱: Anti-WEE2 rabbit polyclonal antibody
別 名: WEE1B
相關(guān)類別:一抗
儲(chǔ) 存: 冷凍(-20℃)
宿 主: Rabbit
抗 原: WEE2
反應(yīng)種屬: Human
標(biāo) 記 物: Unconjugate
克隆類型: rabbit polyclonal
技術(shù)規(guī)格
|
Background: |
Oocyte-specific protein tyrosine kinase that phosphorylates and inhibits CDK1/CDC2 and acts as a key regulator of meiosis during both prophase I and metaphase II (PubMed:29606300). Required to maintain meiotic arrest in oocytes during the germinal vesicle (GV) stage, a long period of quiescence at dictyate prophase I, by phosphorylating CDK1 at 'Tyr-15', leading to inhibit CDK1 activity and prevent meiotic reentry. Also required for metaphase II exit during egg activation by phosphorylating CDK1 at 'Tyr-15', to ensure exit from meiosis in oocytes and promote pronuclear formation (By similarity). |
|
Applications: |
ELISA, IHC |
|
Name of antibody: |
WEE2 |
|
Immunogen: |
Synthetic peptide of human WEE2 |
|
Full name: |
WEE1 homolog 2 |
|
Synonyms: |
OOMD5; WEE1B |
|
SwissProt: |
P0C1S8 |
|
ELISA Recommended dilution: |
5000-10000 |
|
IHC positive control: |
Human liver cancer and Human colorectal cancer |
|
IHC Recommend dilution: |
25-100 |
購物車
幫助
021-54845833/15800441009
